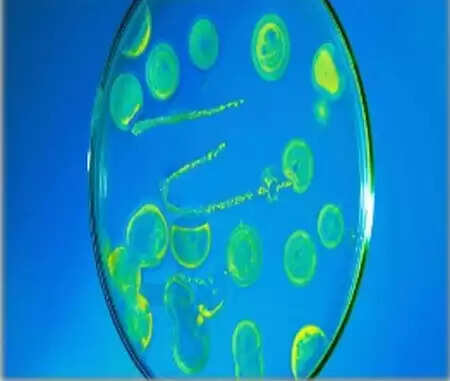

തിരുവനന്തപുരം മെഡിക്കല് കോളജിലെ ഡയാലിസിസ് യൂണിറ്റില് അണുബാധ; ബര്ക്കോള്ഡേറിയ ബാക്ടീരിയ ബാധ സ്ഥിരീകരിച്ചത് 6 രോഗികള്ക്ക്, ബാക്ടീരിയ ബാധ ഇത് മൂന്നാംതവണ
Jul 10, 2018, 12:22 IST
ADVERTISEMENT
ADVERTISEMENT
ADVERTISEMENT
ADVERTISEMENT
ADVERTISEMENT
ADVERTISEMENT
തിരുവനന്തപുരം: (www.kvartha.com 10.07.2018) തിരുവനന്തപുരം മെഡിക്കല് കോളജിലെ ഡയാലിസിസ് യൂണിറ്റില് അണുബാധ കണ്ടെത്തി. ഡയാലിസിസിന് വിധേയരായ ആറുരോഗികളിലാണ് ബര്ക്കോള്ഡേറിയ എന്ന ബാക്ടീരിയ ബാധ കണ്ടെത്തിയത്. അതേസമയം അണുവിമുക്തമാക്കി പ്രവര്ത്തനം പുനഃരാംഭിച്ചതായി ആശുപത്രി സൂപ്രണ്ട് അറിയിച്ചു.
ഇത് മൂന്നാം തവണയാണ് സൂപ്പര് സ്പെഷ്യാലിറ്റി ബ്ളോക്കില് പ്രവര്ത്തിക്കുന്ന ഡയാലിസിസ് യൂണിറ്റില് അണുബാധയുണ്ടാകുന്നത്. ഈ വര്ഷം രണ്ടാമത്തെ തവണയും. നേരത്തെ ഏപ്രിലിലും ജൂണിലുമായി ആറു രോഗികളില് അണുബാധ സ്ഥിരീകരിച്ചിരുന്നു. മണ്ണ്, വെള്ളം എന്നിവയില് കൂടിയാണ് പ്രധാനമായും ഈ ബാക്ടീരിയ പകരുന്നത്. ആശുപത്രിയിലെ കുടിവെള്ള ടാങ്കില് നിന്നാണ് ബാക്ടീരിയ പടര്ന്നതെന്നാണ് കരുതുന്നത്.
ഡയാലിസിസിന് ഉപയോഗിക്കുന്ന ഉപകരണങ്ങള് അണുവിമുക്തമാക്കുന്നതിലുണ്ടായ പിഴവോ വെള്ളം ശുദ്ധമല്ലാത്തതോ ആകാം ബാക്ടീരിയ ബാധയ്ക്ക് കാരണമെന്ന് കരുതുന്നു. വൃക്ക തകരാറിനെ തുടര്ന്ന് ശാരീരികമായി അവശരായി കഴിയുന്ന രോഗികള്ക്ക് രോഗപ്രതിരോധ ശേഷിയും നന്നെ കുറവാണ്. ബാക്ടീരിയ ബാധയുണ്ടായാല് ശ്വാസകോശം, കരള് തുടങ്ങിയ ആന്തരികാവയവങ്ങളുടെ പ്രവര്ത്തനം തകരാറിലാകാനും സന്ധികളില് നീര്ക്കെട്ടിനും കാരണമാകും.
കാരുണ്യയുടെ ഡയാലിസിസ് യൂണിറ്റ് ഷോര്ട്ട് സര്ക്യൂട്ടില് കത്തിപോയതിന് ശേഷം അവിടെയുള്ള രോഗികളേയും സൂപ്പര് സ്പെഷ്യാലിറ്റി ബ്ളോക്കിലാണ് ഡയാലിസിസിന് വിധേയരാക്കുന്നത്. ഇതോടെ സൂപ്പര് സ്പെഷ്യാലിറ്റിയില് രോഗികളുടെ തിരക്കായി. ഇതിനിടെ നടത്തിയ പരിശോധനയിലാണ് അഞ്ച് മെഷീനുകളില് അണുബാധ കണ്ടെത്തിയത്. ഇവ അണുവിമുക്തമാക്കി വീണ്ടും പ്രവര്ത്തനക്ഷമമാക്കി.
കഴിഞ്ഞദിവസം ഇതുമായി ബന്ധപ്പെട്ട് ആശുപത്രി സൂപ്രണ്ട് വിളിച്ചുചേര്ത്ത യോഗത്തില് ഡയാലിസിസ് യൂണിറ്റിന്റെ വാട്ടര് ടാങ്ക് അണുവിമുക്തമാക്കി ബന്തവസ് ചെയ്യാനും ഡയാലിസിസ് യൂണിറ്റിലെ നിലവിലെ വാട്ടര് ട്യൂബുകള്ക്ക് പകരം സ്റ്റെയിന്ലെന്സ് സ്റ്റീല് പൈപ്പുകള് സ്ഥാപിക്കാനും തീരുമാനിച്ചതോടെയാണ് അണുബാധ സംഭവം പുറം ലോകം അറിഞ്ഞത്.
ഇത് മൂന്നാം തവണയാണ് സൂപ്പര് സ്പെഷ്യാലിറ്റി ബ്ളോക്കില് പ്രവര്ത്തിക്കുന്ന ഡയാലിസിസ് യൂണിറ്റില് അണുബാധയുണ്ടാകുന്നത്. ഈ വര്ഷം രണ്ടാമത്തെ തവണയും. നേരത്തെ ഏപ്രിലിലും ജൂണിലുമായി ആറു രോഗികളില് അണുബാധ സ്ഥിരീകരിച്ചിരുന്നു. മണ്ണ്, വെള്ളം എന്നിവയില് കൂടിയാണ് പ്രധാനമായും ഈ ബാക്ടീരിയ പകരുന്നത്. ആശുപത്രിയിലെ കുടിവെള്ള ടാങ്കില് നിന്നാണ് ബാക്ടീരിയ പടര്ന്നതെന്നാണ് കരുതുന്നത്.
ഡയാലിസിസിന് ഉപയോഗിക്കുന്ന ഉപകരണങ്ങള് അണുവിമുക്തമാക്കുന്നതിലുണ്ടായ പിഴവോ വെള്ളം ശുദ്ധമല്ലാത്തതോ ആകാം ബാക്ടീരിയ ബാധയ്ക്ക് കാരണമെന്ന് കരുതുന്നു. വൃക്ക തകരാറിനെ തുടര്ന്ന് ശാരീരികമായി അവശരായി കഴിയുന്ന രോഗികള്ക്ക് രോഗപ്രതിരോധ ശേഷിയും നന്നെ കുറവാണ്. ബാക്ടീരിയ ബാധയുണ്ടായാല് ശ്വാസകോശം, കരള് തുടങ്ങിയ ആന്തരികാവയവങ്ങളുടെ പ്രവര്ത്തനം തകരാറിലാകാനും സന്ധികളില് നീര്ക്കെട്ടിനും കാരണമാകും.
കാരുണ്യയുടെ ഡയാലിസിസ് യൂണിറ്റ് ഷോര്ട്ട് സര്ക്യൂട്ടില് കത്തിപോയതിന് ശേഷം അവിടെയുള്ള രോഗികളേയും സൂപ്പര് സ്പെഷ്യാലിറ്റി ബ്ളോക്കിലാണ് ഡയാലിസിസിന് വിധേയരാക്കുന്നത്. ഇതോടെ സൂപ്പര് സ്പെഷ്യാലിറ്റിയില് രോഗികളുടെ തിരക്കായി. ഇതിനിടെ നടത്തിയ പരിശോധനയിലാണ് അഞ്ച് മെഷീനുകളില് അണുബാധ കണ്ടെത്തിയത്. ഇവ അണുവിമുക്തമാക്കി വീണ്ടും പ്രവര്ത്തനക്ഷമമാക്കി.
കഴിഞ്ഞദിവസം ഇതുമായി ബന്ധപ്പെട്ട് ആശുപത്രി സൂപ്രണ്ട് വിളിച്ചുചേര്ത്ത യോഗത്തില് ഡയാലിസിസ് യൂണിറ്റിന്റെ വാട്ടര് ടാങ്ക് അണുവിമുക്തമാക്കി ബന്തവസ് ചെയ്യാനും ഡയാലിസിസ് യൂണിറ്റിലെ നിലവിലെ വാട്ടര് ട്യൂബുകള്ക്ക് പകരം സ്റ്റെയിന്ലെന്സ് സ്റ്റീല് പൈപ്പുകള് സ്ഥാപിക്കാനും തീരുമാനിച്ചതോടെയാണ് അണുബാധ സംഭവം പുറം ലോകം അറിഞ്ഞത്.
Keywords: Bacterial infection in dialysis unit of Trivandrum medical college, Thiruvananthapuram, News, Health, Health & Fitness, Medical College, Patient, Drinking Water, Kerala.

ഇവിടെ വായനക്കാർക്ക് അഭിപ്രായങ്ങൾ
രേഖപ്പെടുത്താം. സ്വതന്ത്രമായ
ചിന്തയും അഭിപ്രായ പ്രകടനവും
പ്രോത്സാഹിപ്പിക്കുന്നു. എന്നാൽ
ഇവ കെവാർത്തയുടെ അഭിപ്രായങ്ങളായി
കണക്കാക്കരുത്. അധിക്ഷേപങ്ങളും
വിദ്വേഷ - അശ്ലീല പരാമർശങ്ങളും
പാടുള്ളതല്ല. ലംഘിക്കുന്നവർക്ക്
ശക്തമായ നിയമനടപടി നേരിടേണ്ടി
വന്നേക്കാം.